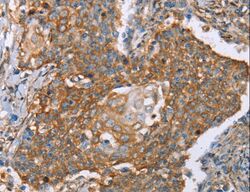

Antibody data
- Antibody Data
- Antigen structure
- References [0]
- Comments [0]
- Validations
- Western blot [1]
- Immunohistochemistry [5]
Submit
Validation data
Reference
Comment
Report error
- Product number
- LS-C405229 - Provider product page

- Provider
- LSBio
- Product name
- PAICS / ADE2 Antibody LS-C405229
- Antibody type
- Polyclonal
- Description
- Affinity purification
- Reactivity
- Human, Mouse, Rat
- Host
- Rabbit
- Isotype
- IgG
- Storage
- Store at -20°C. Avoid freeze-thaw cycles.
No comments: Submit comment
Enhanced validation
- Submitted by
- LSBio (provider)
- Enhanced method
- Genetic validation
- Main image

- Experimental details
- Western blot analysis of HeLa, K562, Raji and Jurkat cell, using PAICS Polyclonal Antibody at dilution of 1:550.
Supportive validation
- Submitted by
- LSBio (provider)
- Enhanced method
- Genetic validation
- Main image

- Experimental details
- Immunohistochemistry of paraffin-embedded Human cervical cancer using PAICS Polyclonal Antibody at dilution of 1:50.
- Submitted by
- LSBio (provider)
- Enhanced method
- Genetic validation
- Main image

- Experimental details
- Immunohistochemistry of paraffin-embedded Human esophagus cancer using PAICS Polyclonal Antibody at dilution of 1:50.
- Submitted by
- LSBio (provider)
- Enhanced method
- Genetic validation
- Main image

- Experimental details
- Immunohistochemistry of paraffin-embedded Human cervical cancer using PAICS Polyclonal Antibody at dilution of 1:50.
- Submitted by
- LSBio (provider)
- Enhanced method
- Genetic validation
- Main image
- Experimental details
- Immunohistochemistry of paraffin-embedded Human cervical cancer using PAICS Polyclonal Antibody at dilution of 1:50.
- Submitted by
- LSBio (provider)
- Enhanced method
- Genetic validation
- Main image

- Experimental details
- Immunohistochemistry of paraffin-embedded Human esophagus cancer using PAICS Polyclonal Antibody at dilution of 1:50.